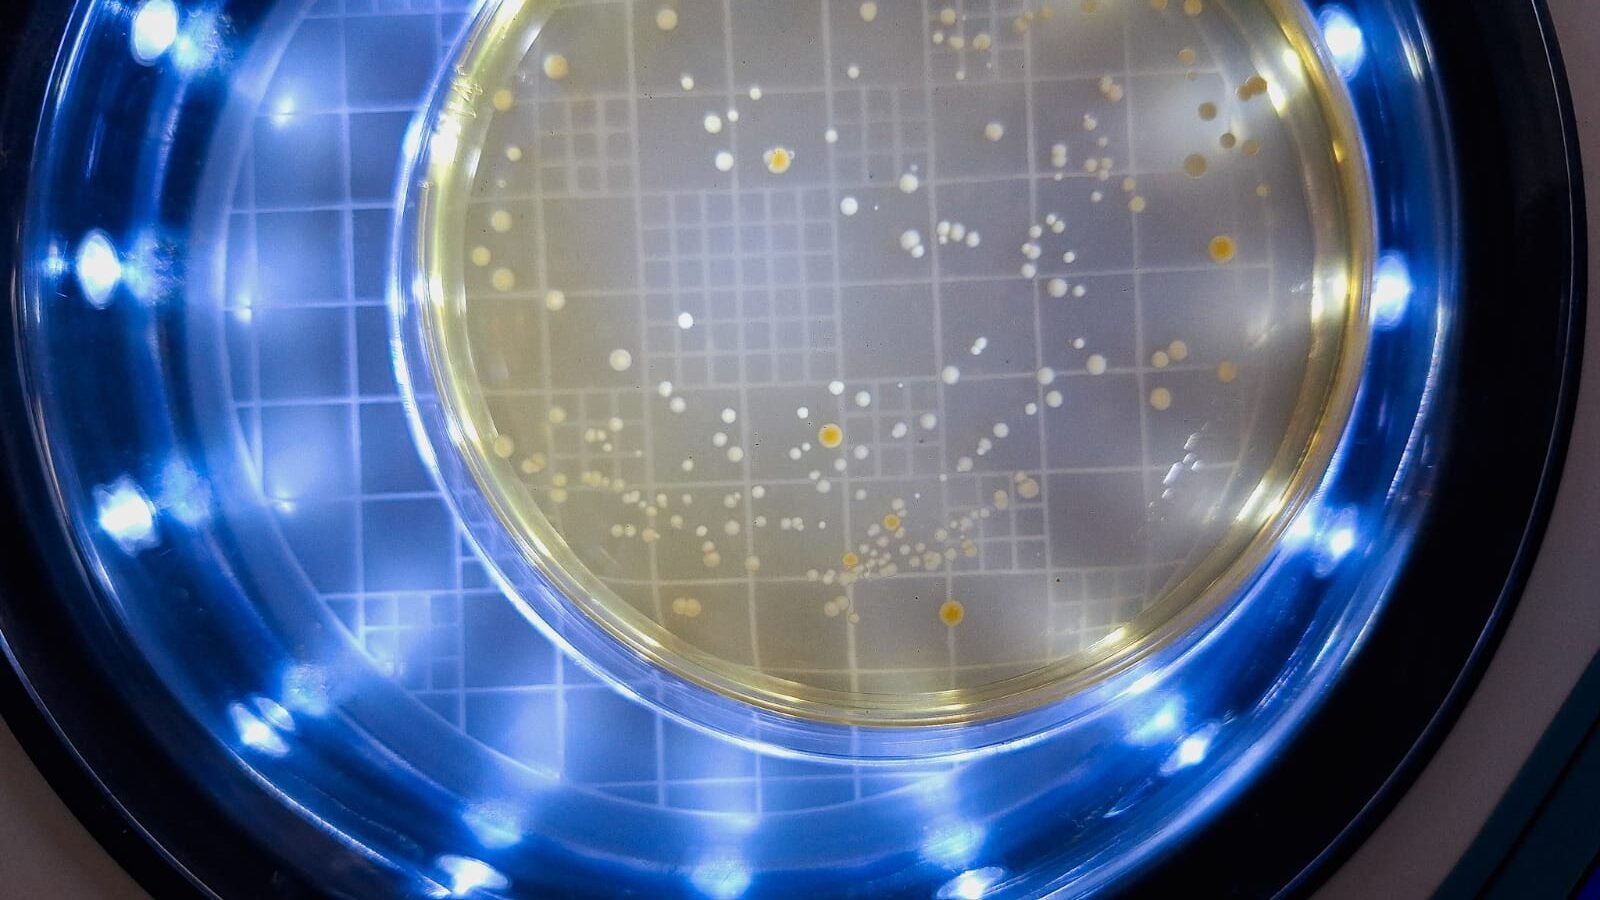

Evento acontece a partir desta terça-feira (14), em Belo Horizonte

(Belo Horizonte – 13/4/2026) A Conferência Internacional Novas Tendências na Identificação Microbiana (ID Microbiana) será realizada entre os dias 14 e 17 de abril, em Belo Horizonte. O evento é uma organização conjunta entre a Empresa de Pesquisa Agropecuária de Minas Gerais (EPAMIG), Soluções para Eventos Científicos (SEC) e Micoteca da Universidade do Minho (MUM).
A programação vai discutir avanços em metodologias e tecnologias aplicadas à identificação de microrganismos presentes na composição de produtos alimentícios, biomédicos e ambientais e celebrar os 30 anos da Coleção Microbiana – Micoteca da Universidade do Minho. As atividades terão início às 13h, desta terça-feira (14) no auditório da Sede da EPAMIG.
“A conferência vai reunir especialistas, pesquisadores e profissionais de diferentes países para discutir tecnologias de identificação de microrganismos, em especial MALDI-TOF MS, FT-IR e biologia molecular (LAMP), por meio de uma abordagem interdisciplinar, que abrange áreas da microbiologia ambiental, agroalimentar e biomédica”, define a chefe do Departamento de Pesquisa da EPAMIG, Cristiane Viana, que integra a Comissão Organizadora do evento.
Além de palestras e demonstrações, o evento será composto por apresentações orais e de pôsteres e momentos de networking. Ao final das atividades está prevista a celebração de memorandos de entendimento com o World Data Centre for Microorganisms (WDCM), que pertence ao Instituto de Microbiologia da Academia Chinesa de Ciências.
A Conferência Internacional ID Microbiana é presidida pelo professor Nelson Lima, presidente da Federação Mundial de Coleções de Culturas Microbianas (WFCC) e diretor da Micoteca da Universidade do Minho e pelo diretor da Soluções para Eventos Científicos (SEC), Ricardo Meirelles Cruz, também integram a Comissão Organizadora, o pesquisador da EPAMIG Daniel Arantes e a professora do Instituto Federal de Minas Gerais (IFMG) Fabiana Couto.
A realização do evento conta com a parceria da Rede Mineira de Pesquisa em Queijos Artesanais.



